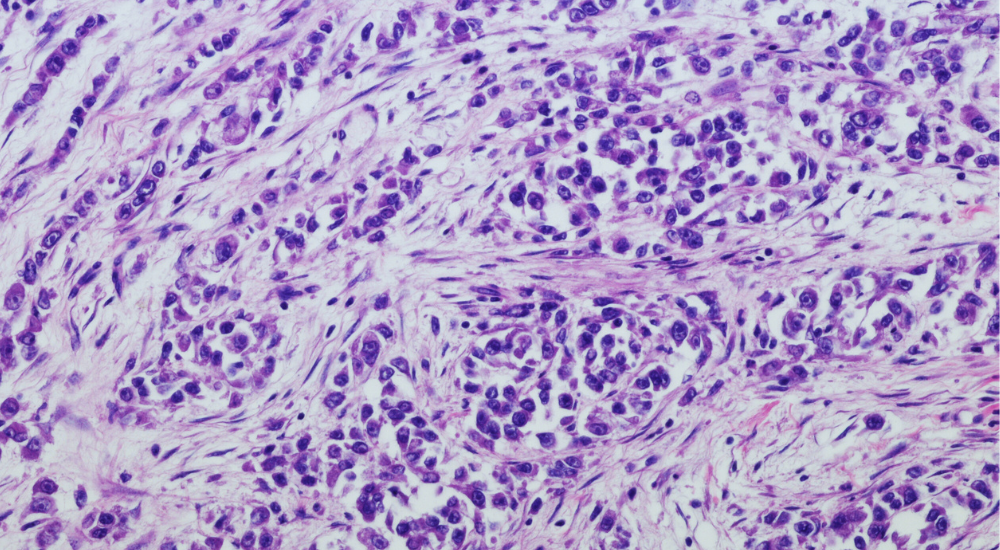

Harmonisierung und Standardisierung der bildgebungsbasierten Datenerhebung
Als erstes Projekt dieser Größenordnung soll BORN eine sichere IT-basierte Netzwerkstruktur mit dem Ziel einer Harmonisierung und Standardisierung der bildgebungsbasierten Datenerhebung inklusive strukturierter und standardisierter Befunderhebung errichten und damit bildgebende Datensätze bei onkologischen Erkrankungen einheitlich erfassen und auswerten. BORN ergänzt das Bayerische Zentrum für Krebsforschung (BZKF) um eine vernetzende Komponente, welche die gemeinsame Standardisierung, Auswertung und Etablierung quantitativer, bildbasierter Biomarker unterstützt. BORN soll hierbei auf während der Covid-19-Pandemie etablierte Strukturen in der universitären Radiologie (RACOON) aufbauen. Insbesondere für die Etablierung von KI-Anwendungen stellen große standardisierte Datensätze eine Grundvoraussetzung dar, wobei die Daten dezentral in den einzelnen Kliniken verbleiben sollen. Gemeinsam mit der Firma Brainlab AG und deren Tochtergesellschaft Mint-Medical GmbH erarbeiten und etablieren die Projektpartner einheitliche, strukturierte und standardisierte Befundberichte in der onkologischen Bildgebung in den sechs bayerischen Universitätskliniken für vorerst sechs Tumorarten.
Befundungstemplates
Zur Erfassung der onkologischen Daten wurden an allen 6 radiologischen Standorten Untersuchungsprotokolle und Befundungstemplates entwickelt. Damit entsteht eine Datengrundlage, die für Wissenschaftlerinnen und Wissenschaftler, aber auch für Medizinproduktehersteller und für die Pharmazeutische Industrie genutzt werden kann.
Ausblick
In einem weiteren Schritt sollen die im BZKF BORN-Projekt entwickelten Untersuchungsstrategien auf andere Krankenhäuser und Radiologische Praxen übertragen werden – sodass Patientinnen und Patienten in ganz Bayern davon profitieren.
Pressemitteilungen des BORN-Projekts: